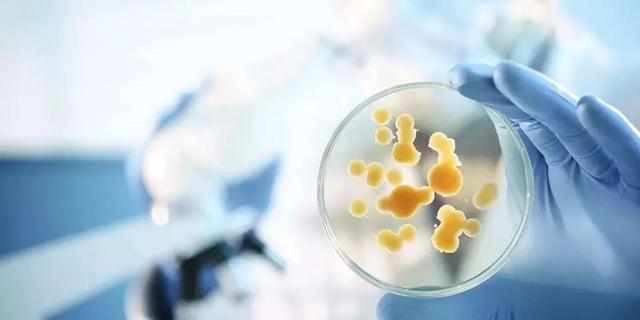
FDA鎸囧崡,鎸囧崡寮曢鍏变績鎴愰暱

连续制造简称CM,是Continuous Manufacturing的英文缩写。可以说,制药行业连续制造概念的推出,是又一个技术变革的代表。连续制造(CM)不仅仅会解决药品短缺,提高工作效率;在实施连续制造的同时,促进相关过程监控技术和自动化技术的发展,并为制药行业智能制造提供促进的环境。
2019年初,FDA推出指南《Quality Considerations for Continuous Manufacturing》,代表着美国官方FDA对此问题的正式化和继续深化,这份指南在中国制药行业也引发广泛关注。
其实,在这份指南发布之前,FDA已经在官网推出了一份涉及CM的指南在征求意见。只是这份更早发布的指南不是FDA起草的,而是FDA委托C-SOP(Center for Structured Organic Particulate System)组织起草的;这份文件名称是《Current Recommendations for Implementing and Developing Continuous Manufacturing of Solid Dosage Drug Products in Pharmaceutical Manufacturing》。
为了让中国制药行业同仁更好的了解美国制药行业对CM的最新认识,本人翻译了这份指南的核心部分,并给与解析。(下面文本编号是原来指南的编号)
文末有彩蛋
2.固体制剂连续制造的关键方面
2.1.固体制剂药物连续制造的基本工程概念和定义
任何生产工艺都应该从系统规模、单元操作规模和散装物料规模三个维度进行研究,以获得支持合理设计和有效实施的工作理解。这当然适用于任何连续制造工艺,这是一个具有多个高度集成的单元操作以相同的速度同步运行的系统。要设计、优化和控制这样的系统,通常重要的是研究、定义和建模系统及其单元操作。
应在系统层面考虑优化和分布式控制,因为每个单独的单元操作的最佳条件不会导致综合系统的最佳性能,有时甚至是可行的性能。
任何生产工艺的基础都是单元操作。单元操作被定义为工艺中的一个基本步骤。单元操作的目标是对输入的材料进行物理或化学变化,以最终将其转化为完整的产品。
转换可以包括混合、聚集、碾磨、涂层、整合、分离、结晶、蒸发、过滤或化学反应。
单元操作可分为三类:批、半连续(半批)和连续。根据物料进入和离开工艺环节的方式,单元操作被分为这些类别。批操作包括按顺序装载一定数量的物料,处理该质量,然后放出所有转化的物料。另一方面,连续操作包括不断装载、加工和放出物料,而不会中断。
半连续操作具有批和连续两种要素,即物料不断装载或从工艺中不断移除,但也不是没有中断。
为了生产出质量可靠的产品,所有的单元操作都需要处于受控状态。控制状态可以定义为一组控制一致地提供持续工艺性能和质量保证的条件。
与批或半连续单元操作不同,连续单元操作可以设计为在控制状态的子集(称为稳态状态)下或其附近运行。一般来说,稳态条件被定义为工艺状态,其中IPCs, CPPs和/或质量属性保持近似恒定,或者在相关时间跨度内,这些变量的时间变化率大约等于零。在商业实践中,确实会发生变化,但偏离稳定状态的偏差很小,足以忽略或可控。连续系统的输出变量保持在期望的范围内,处于动态控制状态。
连续、稳态过程的时不变性质以及处于动态控制状态的连续系统的近时不变性质,使其相对于时变批处理具有重要的优势。这些优势大多源于这样一个事实:当某些东西发生变更时(要么是由于设备变更导致的工艺参数变化,要么是由于进料变更导致的物料变化,或者是影响工艺的环境变化),可以检测到这些变化。
当发生变更而系统经历一个动态周期(随时间变化),这种周期称为瞬态。批和半连续单元操作始终处于瞬态状态,需要更深入的工艺知识来了解工艺是否遵循正常轨迹。因此,与本质上的时变过程相比,更容易证明稳态过程的控制状态(无论是静态还是动态)。这并不排除稳态或非稳态过程中的瞬态被证明处于控制状态。
在连续制造中,物料在整个生产过程中所需的时间通常对单元操作的性能和整个系统的可控性至关重要。在稳态单元运行中,平均停留时间的定义为单元运行中包含的物料量(通常称为滞留或停留量)除以物料进入/离开系统的速度。平均停留时间可以看作是单元操作对物料进行物理或化学转化的平均处理时间。
如果进入单元操作的所有物料在单元操作中花费相同的时间,则称为塞流系统。在塞流系统中,所有物料的停留时间与平均停留时间相同。塞流式系统不会对沿其流动方向的物料进行任何混合,也无法消除进入系统的任何波动。实际上,所有的系统都会对通过系统的物料的停留时间产生一些变化。由于停留时间的变化比停留在系统内的总时间变小,系统被认为是"更多的堵塞流"。
与塞流式系统相比,连续搅拌槽反应器(CSTR)系统是一种理想的系统,其中,进入装置的部件在进入装置运行时立即与装置运行中的所有物料混合。在CSTR中,物料在工艺中的时间变化很大。理论上,任何进入单元操作的物料都有真正的(尽管很小)机会立即离开罐或永远留在罐内。与理想塞流概念一样,理想CSTR混合系统是一个抽象概念,但它可以看作是近似的良好混合系统的行为。
当物料进入系统时,与进入储罐的任何一段相关的可能停留时间的分布称为停留时间分布(RTD)。对于任何特定的单元操作,停留时间分布(RTD)描述了物料基本单元在系统中可能停留的时间分布,以及在系统中花费特定时间的物料比例。
如果固体口服制剂连续生产系统是一个完美的塞流系统,那么它将有一个类似于delta函数的停留时间分布(RTD),并且变异性或噪声将直接通过系统传播,并导致最终产品含量均匀性随时间(位置间变异性)发生含量变异。为了对抗这种馈电噪声,可以有意地将工艺设计为具有更宽的RTD。如果这个更宽的RTD设计正确,它将混合馈线变异性回到平均值。这有时被称为系统内的反向混合程度。RTD的宽度可以用来计算系统的反混合(分散)系数。
由于停留时间分布(RTD)与单元操作的混合能力直接相关,因此经常在单个单元操作上下文中讨论RTD。然而,按顺序单元操作的RTDs可以组合起来创建一个系统RTD,表示从给定入口到整个系统出口的停留时间分布,这可能被用作主动控制策略的一部分。当将多个连续操作连接在一起形成一个系统时,瞬态通过线路传输所需的时间量成为重要的度量指标。这就是所谓的特征时间。特征时间可以用来预测瞬态或工艺变更离开系统需多长时间, 系统过渡到一个新的稳定的状态需要多长时间,以及哪个产品单位会受到瞬态的影响。
2.2.常见的药品概念和连续批次的定义的关键区别
本节介绍并初步讨论一些关键主题,这些主题虽然在本文档的其他地方已经讨论过,但值得进行高层次的概述,因为这些主题在如何应用于批处理和连续处理方面的差异可能在很大程度上有所不同。
2.2.1. 工艺分析技术(PAT)
自从FDA发布PAT行业指南-创新药物开发、制造和质量保证的框架,越来越多的重点放在了获取中控数据的工具的使用上。PAT经常提到光谱/化学计量工具,这些工具通常只监测配方中的API。这已应用于批次固体制剂应用中,如混合均匀度测量。这些工具在先进的制药生产应用中非常有用,也是获取化学特异性(API)信息的主要手段,尽管它们目前在商业实践中需要进行重要的化学计量学模型维护,这可能会阻碍其应用。
连续制造为使用光谱/化学计量PAT工具以及重要的非光谱和工艺分析数据的软传感器源提供了额外的机会。根据FDAPAT指南-创新药物开发、制造和质量保证的框架中的定义,PAT是一个设计、分析和控制制造的系统,通过及时的测量(即在生产过程中),对原材料和工艺的关键质量和性能属性进行评估,以确保最终产品的质量。值得注意的是,PAT中的术语"analytical"被广泛认为包括以综合方式进行的化学、物理、微生物、数学和风险分析。与固体制剂批次制造相比,连续制造系统的集成特性使符合PAT定义的方法和数据源数量显著增加。。与连续制造相关的PAT包括重要的非光谱或用于工艺监控的工艺分析数据的软传感器源。在许多情况下,非光谱工艺数据虽然不具有化学特异性,但可以更快地获得和分析,同时比光谱数据更稳健,更容易解释。此外,当适当地与其他数据聚合时,非光谱信息可以提供更广泛、更完整的系统状态表征。
2.2.2.连续工艺批次的定义
从21CFR210.3开始的批次的基本概念是相同的,无论是通过批次生产还是连续加工。"批次"是指在规定的限度内,按照同一生产周期的单一生产指令生产的具有统一性质和质量的特定数量的药品或其他物料。
定义连续制造工艺的批次比在批次生产工艺中有更多的选择,因为有许多可接受的法规方法。运行过程中批量大小的灵活性是连续制造的一个重要优势,它使每个批大小能够及时变化以支持订单供应链策略。任何单个运行的批大小都可以在该运行开始之前指定。
受质量处置决策影响的物料数量可以定义为:
o在两个特定的时间内从生产过程中释放出来的所有物料(不论生产的物料数量)。
o生产的特定数量的物料(无论所用时间)。
o在两个特定的工艺事件(例如,特定的工艺条件)之间产生的所有物料。
o所有"有意"包含特定批次或数量的特定输入物料。
o以及申请人认为合理的其他情况(例如,由一袋药物制成的产品数量,或x kg/h)
连续工艺可以在没有预先定义的最大运行时间的情况下运行,在该工艺的运行过程中,根据科学和风险原则(例如,在某一时间生产的任何实体,或包含某一批起始材料)以灵活的方式定义产品数量,并且服从处置决策。
这些决策需要在任何生产运行开始之前作出,但将为不断变化的市场需求提供更大的灵活性。
根据批次的定义,只要充分评估运行时间问题(如物料堆积、热量产生等)并降低风险,并在验证生命周期中由申请人的质量体系控制进行评估,连续工艺批次大小将不受试验/生物批次规则的10倍大小的限制,因为更相关的参数是流速,通常为kg/h,而不是每批次的kg数。批次大小可注册为单个值、经验证的可接受范围(如最小和最大值)或设计空间,包括两个或多个参数(如速率和时间)。
在PRA或设计空间内的变动不会被视为变更。随着得到的更多的经验和数据,在产品生命周期的后期,变动可能会超出范围。监管机构的通知将遵循与CPP、PAR、NORS或设计空间相同的指导原则,这取决于如何对批量大小定义进行分类。
对于上市后的变更,批量的减少不应要求与运行时间延长一样多的信息,因为运行时间缩短,诸如物料堆积、热量生成等问题的重要性会降低。但是,运行时间缩短可能会影响采样计划和生成的数据总量。
应利用为确定批量大小/持续时间变化对产品质量的影响而进行的风险评估来证明报告类别的合理性。
中控中的广泛监控对产品质量提供了高度的信心。证明产品质量对批量/运行时间扩展是可接受的,应为将来的使用提供理由。
质量体系中包含的工艺验证策略应根据法规文件中的定义以及证明连续工艺能够持续交付高质量产品的方法,概述已验证工艺的边界。根据所选的批定义,活动的长度可以是灵活的、非规定性的。只要保持工艺的控制状态,批次的持续时间可能不重要。工艺运行的最长时间可以通过监控特定产品属性或工艺参数来确定,而不是通过验证运行时间单一固定的长度或范围来确定。
2.2.3.过程监控和控制
根据ICH Q10,控制策略是一组计划好的控制手段的组合,源于对当前产品和工艺的理解,以确保工艺性能和产品质量。这些控制可以包括与药物和成品物料和组分、设施和设备操作条件、中间控制、成品标准以及相关的监测和控制方法和频率相关的参数和属性。
连续制造系统的集成特性为使用中间监控提供了更多的机会。与批次工艺相比,中间控制在连续工艺中可能扮演更大的角色,因为单元操作之间没有停顿,因此从效率和法规遵从性的角度来看,需要一个自动化的中间测定、控制和行动计划。
可以对固体制剂药物连续制造工艺的控制策略进行设计,以根据工艺、设备条件、进料原材料或环境因素随时间的潜在变化,来控制产品质量。控制策略的实现通常可以分为三个层次,它们具有不同的复杂性和健壮性/灵活性。参见Sau L. Lee等。在实践中,控制策略可能包含这三个层次的所有元素。在任何情况下,都必须减轻和控制质量风险。
采用由特定加工设备组成的特定生产配置,在确保制造合格产品所需的范围内操作,选择性使用传感和闭环控制配置,以保持产品处于适当的动态控制状态,可能构成既定条件的要素,只要FDA批准时的工艺理解的状态表明这些条件被认为是确保产品质量合格的必要条件。在既定的操作范围内对特定工艺参数值的更改并不构成对既定条件的更改,因为它们是实现闭环控制策略的内在要求。
2.2.4.数据存储和处理
连续制造系统会比批次制造系统创建更多的数据。从运营的角度来看,这既是机遇也是挑战。增加数据存取可更多地利用统计决定,从而可进行更具代表性的抽样和报告。
但是,随着数据量的增加,必须在设计和确定哪些信息是内部记录/报告系统的一部分、记录数据必须保存多长时间以及以何种形式保存等方面作出决定。对于大量的数据,会有虚假的数据点,必须以适当的统计支持方式理解和处理。
2.2.5.工艺建模
与批次生产系统相比,连续生产系统更易于建模。
模型试图从单元操作中预测输出属性,并将其作为输入物料特性和工艺参数的函数。模型可以预测稳态输出,或者更有用的预测单元操作对输入物料或加工条件变化的动态响应。该模型还可用于预测物料性能、工艺参数等的瞬态变化。
单个单元操作的模型可以组合成多个单元操作甚至整个制造系统的"流程图"模型,包括本地和分布式控制系统的影响。这种集成模型实际上对设计、调整和优化控制系统很有用。
这些模型,一旦通过与实验数据的比较得到适当的验证,就可以用来检验系统相对于瞬态的稳健性,无论是单独的还是组合的。模型所支持的处理扰动的策略可以包括实施控制策略,以减轻瞬态对产品质量的影响,以及使用模型预测何时应将故障产品排除在输出流之外。
一个经过实验验证的模型可以作为公司建立制造系统稳健性和可靠性策略的一部分。
3.连续固体口服制剂生产工艺的生产收集和取样
3.1.产品测试和放行的策略
3.1.1.可接受标准
一般来说,除非特殊情况需要,否则使用连续系统生产的药品的关键质量属性(CQAs)的验收标准不一定与用于批次工艺的标准不同。与传统的批次工艺一样,对于连续生产的工艺验证和常规放行可以建立不同的标准。工艺确认(第二阶段)标准应提供高水平的保证,确保相关标准或药典标准能够在商业生产之前得到满足,如FDA工艺验证指南:一般原则和实践中所述。由于在工艺验证过程中要实现的目标不同,在持续过程验证(阶段3)和常规放行过程中采样计划可能存在差异。
3.1.2. 连续制造工艺相关的产品测试和放行的取样计划考虑
对于均匀性测试(例如,含量均匀性),任何抽样计划的目标都应该是确保放行数据具有代表性,确保所处理物料的均匀性。
虽然产品放行测试的取样计划是确保批次具有可接受的一致特性的一个重要要素,但其他要素也可用于连续制造,以确保批次具有可接受的一致特性(例如,工艺参数监测数据分析、采用光谱或非光谱技术对过程中材料属性进行监测)。
对于第一阶段(工艺设计)、第二阶段(工艺确认)和第三阶段(持续工艺验证),使用不同的抽样计划是可以接受的,因为不同阶段的试验目标不同。取样计划可以考虑物料和工艺风险评估以及工艺动力学、工艺理解和工艺能力。
早期临床试验材料生产的取样计划可能不同于后期生产,这取决于工艺理解和在线/在线PAT模型(包括光谱和非光谱传感器数据)的可用性。
固体制剂连续制造工艺的取样计划应概述取样频率和从每个给定取样点采集和/或测试的样品数量。从取样计划收集的数据将根据预先规定的验收标准进行评估。取样计划的频率/分层可根据时间或体积确定。
在适用的情况下,与传统计划(指的是传统的取样规则,也称为大n计划)相比,生成和使用大量(即10倍)数据的抽样计划可能需要不同于传统计划的统计标准。这样"大n"计划能够以更大的统计置信度检测出有缺陷的产品。因此,这些计划可能允许更大的RSD标准,因为标准偏差的估计包含较少的不确定性。相反,与传统计划相比,"大n"计划在任何给定时间间隔外检测单个值的概率更大,这不是因为产品质量差,而是因为它们收集了更多的样本。因此,大n"计划抽样计划必须完全基于平均值和标准差的标准(即置信区间标准),而不需要绝对区间。
但是,应该注意的是,也可以采用绝对间隔(例如75-125%)来加强控制策略,以防止剂量单位中药物含量极低或很高。
3.1.3.实时放行测试注意事项
实时放行测试(RTRT)是"基于工艺数据评估和确保工艺过程中和/或最终产品质量的能力,这些数据通常包括测量的物料属性和工艺控制的有效组合"。
虽然连续制造不需要实施RTRT方法,但使用质量源于设计的方法开发合适的药品,采用连续工艺可以更有效、更高效地实现。通常,与批处理工艺相比,能够通过相互联系的单元操作进行多个快速的工艺变更,可以更有效地使用物料,易于实现设计的实验。此外,连续加工方法允许从采用PAT方法校准和验证的实验设计(DOE)中实时生成实验样品(片剂)。从丰富的数据集之中获得的结果知识可以通过开发预测性CQA模型或与直接在线/在线测量物料中间属性相结合,使人们对设计空间和关键工艺参数(CPP)相互作用有更大的过程理解,这更适合RTRT方法。例如:用于片剂或混合原料药浓度的近红外光谱(NIR)与自动片剂重量测量相关联,用于实时分析鉴别、含量均匀性和含量测定。
应该补充的是,一些中间控制(IPC)可能不是RTRT的一部分;但是,非RTRT IPC的性能可能需要从风险评估的角度考虑,作为RTRT控制的操作偏差或停机时间的缓解措施(例如NIR维护)。
3.2.不合格物料的产品收集/隔离方法
连续制造中,通过进一步地监测和控制,可以将可能无法接受的产品从最终收集流中转移出来。这与光谱或非光谱PAT(可能与RTRT)的使用以及控制策略密切相关,在第二阶段工艺确认期间,在第三阶段持续工艺验证之前,可以建立描述何时收集和何时转移产品的程序。
在适当的时候,还可以在第二阶段工艺确认过程中考虑处理不符合趋势(而不是不合标准)的产品的程序,以及相关的非在线取样策略。此外,还应确定在生产过程中应对工艺异常的收集标准的考虑因素。
根据工艺异常的严重程度和对连续制造单元中分散/停留时间分布的理解,此类工艺异常可能导致增加抽样/测试计划,以确保产品质量。但是,如果工艺异常足够严重(严重程度和/或持续时间),以至于预期会导致产品不符合收集标准,则可能会对相关的一些批次进行隔离和/或拒收。
对整个停留时间分布的评估,以及对系统中提取点之间瞬态传播的理解,对于证明由于意外事件或瞬态而处于危险中的物质数量是很重要的。
虽然产品收集标准启动/关闭可以指产品效力和/或与连续制造的一致性,可能是期望产品收集开始时遵循的方法类似于批次生产(压片操作是连续的,通过设计)压片启动程序已建立的方法。控制策略可以提出并证明产品收集标准,这些标准可以建立在实际的在线/在线CQAs测量或相关CQAs的替代测量之上,也可以建立在适当的设备设计和工艺理解/工艺建模之上。
4.适用于固体制剂连续制造现有的指南和标准
尽管存在显著的差异,但为批次生产过程编写的现有指导文件的许多元素都可以与连续制造工艺相关。
ASTM E2968-14,连续加工在制药工业中的应用标准指南,包含了连续制造元素的全面信息。本文件可能是关于药品连续生产的最新、简明和相关的信息。
ASTM E2587 -在统计工艺控制中使用控制图的标准操作规程包含非常有用的控制图应用指南,以帮助解释稳态数据。
ASTM E2281 -工艺和测量能力指数的标准实践,包含了如何评估工艺性能的指南,相对于适当的限度计算风险并告知下游控制策略的选择。
适用的FDA指导文件包括:
PAT -(1)创新药物开发、制造和质量保证的框架,
(2)口服药物产品的BA和BE研究-一般考虑,
(3)工艺验证:一般原则和实践
(4)药品化学、制造和控制信息。
本文件其他各节已酌情提到这些问题。
许多ICH质量指南文件的某些方面也适用于连续制造,因为基准质量标准保持不变,无论生产过程的类型如何。所有Q3B到Q3D均适用于连续制造工艺。Q3D的风险评估方法可能需要考虑药物加工过程中元素杂质随时间增长的任何可能性。产品必须符合ICH Q6A《新药和新制剂化学物质检测程序和验收标准》中规定的要求。对于连续制造工艺,可以允许周期性或跳跃性测试、参数放行和中控测试部分。应通过持续生产促进采用中控属性的监控来代替最终产品测试。
ICH Q8(R2)药物开发的编写水平允许其应用于连续制造工艺。它强调以科学和基于风险的整体方法来实现增强产品和工艺理解和控制策略。ICH Q8(R2)还提到了先进的控制系统和建模,以及监管灵活性(设计空间)。可用于连续制造的广泛的工艺监控/反馈系统有可能实施控制策略,这些控制策略较少地基于参数,而更多地基于连续质量监控。重要的是,依靠对工艺参数的控制不会妨碍这些替代控制策略方法的实施。
ICH Q9中定义的风险评估方法可直接应用于连续制造。连续制造工艺和控制策略的复杂性越高(可能影响产品质量的潜在变量越多),风险评估的规模就越大。ICH Q10(药物质量体系)也适用于连续制造,尽管它可能需要修改以适应先进的控制策略和连续制造系统生成的大量数据。
包含可用于连续加工元素的其他ASTM标准,包括E2363制药工业过程分析技术术语、E2475制药生产和控制工艺理解指南、E2537制药和生物制药生产连续质量验证应用指南、E2898 PAT应用分析方法风险验证指南。
稳定性
ICH Q1A(R2)新药和制剂的稳定性测试适用于连续制造工艺。但是,确定主要稳定性批次的数量和大小可能与本文件中的建议方法不一致。例如,连续加工的批量大小应该是灵活的。因此,1/10的比例意味着什么?最长运行时间或数量的十分之一?此外,从一个较长批次中获得的信息,在该批次中可能有多个启动和关闭,以及热量生成和剩余材料积聚,可能优于或不优于从三个小规模(1/10)批次中获得的信息。
其他ICH稳定性指导文件要素:ICH Q1B稳定性试验:新药及制剂的光稳定性试验;ICH Q1C ICH新药和新制剂稳定性试验指南附件新剂型稳定性试验;ICH Q1D新药及新制剂稳定性试验的框架和矩阵设计;以及ICH Q1E稳定性数据的评价,也适用于连续制造。
5.连续制造贯穿产品生命周期的申请
5.1.新的化学实体- IND
连续生产可用于新药的开发,包括临床用产品的生产。IND中包含的信息量将比NDA中包含的信息量更少,也不像NDA中包含的信息量那么全面。随着药物进程从I期临床试验发展到III期临床试验,并获得额外的工艺知识,随后对IND的更新将包含更详细的信息。
IPC和放行测试的工艺知识、控制和验收标准应是阶段性的。对于II期临床试验和III期临床试验阶段临床用品的生产,应对中控模型(如混合物的近红外光谱(NIR))的准备/验证水平的期望进行调整,因为化学计量学很可能会随着配方和制造工艺而发展。虽然可以收集PAT信息,但批次放行可能会通过传统的取样和分析程序,直到现代分析方法得到验证,并且可以为物料可追溯性等开发工艺模型。cGMPs将适用于连续制造应用的所有阶段。
5.2.新的化学实体- NDA
批次制造工艺和连续制造工艺提交的要求基本相同。区别在于满足这些要求的方式。
在第一阶段工艺验证阶段进行的首项活动之一:工艺设计,无论开发的是批次制造工艺还是连续制造工艺,都是为产品创建质量目标产品概要(QTPP), QTPP定义了剂型必须具备的性能特征和特性。进行风险评估,以确定QTPP中列出的可能影响CQAs的潜在工艺参数。
进行实验,确定CPPs和CQAs(包括中控/放行测试的操作范围和验收标准)。或者,确定质量属性和工艺参数之间的关系,并开发适当的控制循环来维护该质量属性。研发工艺中的RTRT方法,可能不适用于第1阶段的批次放行。因此,批次放行通常会通过传统的取样和离线测试。在第1阶段获得的配方和工艺知识用于定义控制策略,该控制策略用于确定在第2阶段将使用的商业批生产工艺和控制。
第二阶段:工艺确认,是对第一阶段工艺设计进行评估,并确定其是否能够重复进行商业生产。此时,RTRT方法用于批次放行可能已开发成熟,也可能还不够成熟。
一旦第二阶段:工艺确认被证实,产品就进入了验证的最后阶段,第三阶段:持续的工艺验证。
5.2.1.模块 3.2.P 制剂
模块 3.2.P制剂列出了NDA制剂部分必须包含的必要信息。虽然最初是为批次工艺编写的,但CTD中所述的大多数信息和概念也适用于连续制造工艺。因此,在编写模块3.2.P制剂时,可以使用现有的CTD格式(稍加调整)对药品连续生产工艺进行提交。下面对模块3.2.P中包含的每个部分给予高级评估。
3.2.P.1部分适用于药品连续制造工艺中调整少(如有)的情况。对于可购买多个等级的辅料,辅料的具体等级可在成分表中列出。
3.2.P.2.1部分制剂的组分,应适用于固体制剂药物连续制造工艺有很少(如果有)调整。本部分包含原料药(3.2.P.2.1.1原料药)和辅料(3.2.P.2.1.2辅料)的信息。除了通常提供用于批次工艺的原料药和辅料的信息外,还可以在本节中描述用于允许连续生产的原料药和辅料的任何特定物料属性。
3.2.P.2.2.1部分处方开发,也适用于固体制剂药物连续制造工艺有很少(如果有)调整。由于连续制造工艺可能与批次制造工艺对物料性能的依赖不同,本节将重点讨论如何选择某些等级的辅料来确保可制造性。将适当的物料属性描述作为开发部分的一部分是一种很好的实践。可以讨论在开发过程中对配方的变化,直至商业化配方。剂型所选成分的选择和理由,药物或辅料的关键物料属性(CMA),以及它们如何影响可制造性、性能或稳定性,可能适用于固体制剂连续制造工艺。如果连续制造工艺正在取代批次工艺,则可能需要证明批次工艺和连续制造工艺的生物利用度和生物等效性。批量大小的定义可以使用第2.2.2节中讨论的任何概念或满足相关法律、法规的其他方法来实现。应允许灵活的批量大小。也可能需要对批次(批次的一部分)进行定义,尤其是对非常长的部分进行分段。
3.2.p.2.3部分"制造工艺开发"的目的,在批次和连续制造工艺中保持不变:提供工艺开发数据,证明过程是可靠的、受控的,能够生产安全有效的产品。一些连续制造可能有所不同的领域包括:
-工艺参数操作范围的可接受范围也可能需要解决停留时间
o-控制状态-何时满足;您如何确保工艺保持;如果工艺失控会发生什么(转移;如何检测以及有多少/在哪个点之间)。
o-IPC/分布式控制系统(DCS)-PAT可与IPC/DCS一起使用;
反馈/前馈、模型开发和维护;采样间隔以及与停留时间和返混的关系。
o-批次放大-运行时间更长、不同的生产量或尺寸不同的设备
o-模型-讨论不用于放行的工艺模型和化学计量学模型。
3.2.P.2.5部分微生物属性,应适用于持续制造工艺。清洁程序和清洁频率应在PQS中加以描述。
3.2.P.3.2部分"批处方",需要针对连续制造工艺进行调整。尽管连续制造工艺的剂量单位处方可能不会与批次生产工艺的剂量单位配方不同,但连续制造工艺的批量大小不同,因此批处方会不同。此外,批量大小可表示为速率(例如,40 kg/h)的函数,而不是质量(例如,400 kg)。允许批量大小的灵活性,并有理由。本节可以链接到批和批次的描述。
3.2.P.3.3,制造工艺和工艺控制的描述,与批次工艺对应物具有相同的用途,尽管它将进行调整以适应连续制造工艺、设备和监控。它可以包括一个流程图,其中包含按顺序的生产步骤以及在每个步骤中实施的IPC。对于2级和3级控制策略,应描述CPP的操作范围(NORS、PAR、设计空间)和非关键工艺参数的PAR。对于1级控制策略,本节还可以描述质量属性的目标和范围,以及控制这些属性的工艺参数。这可以代替传统的CPP/PAR方法。生产描述将包括不同设备的操作参数(例如失重式喂料器)以及用于描述设计空间的模型。
3.2.p.3.5部分工艺验证和/或评估,可根据2011年1月FDA工业指南-工艺验证:一般原则和实践进行。本指南文件确定的所有三个验证阶段(第一阶段:工艺设计、第二阶段:工艺确认、第三阶段:持续工艺验证)可应用于药品连续制造工艺的开发和商业化。
但是,应该认识到,生产合格物料时,连续工艺在控制状态下运行,而不像传统的批次加工,每一批在时间上不断变化。因此,工艺应在(或接近)稳定状态下持续验证。
3.2.p.4部分辅料控制,适用于药品连续制造工艺。可能需要增加辅料特性的鉴别,以确保它们具有连续制造工艺所需的物料属性,落在规定的设计空间内。超出药典专论及其对照范围的必要等级和物料属性可在本节讨论。
3.2.P.5.1部分成品放行标准,批次生产或连续生产的产品都有要求。批次生产和连续生产之间的差异可能在于可用于证明符合这些标准的测试方法和验收标准。由于连续制造工艺的监测/取样/分析水平可能会更高,因此这种通过连续制造增强的工艺监测和控制有助于使用RTRT和/或大N方法,而不是传统的最终产品测试取样和分析技术。RTRT可利用基于统计的抽样计划和验收标准(包括大N验收标准)收集的信息。满足这些标准将确保符合标准中列出的试验(例如,USP<905>剂量单位的均匀性)。
3.2.P.5.2部分分析方法,适用于药品连续制造工艺,尽管它的重点可能从实验室分析技术(如高效液相色谱法)转移到在线方法(如近红外光谱法)。如果实验室分析技术用于离线IPC和放行测试,那么这一部分应该不会改变太多。
但是,如果批次放行使用PAT方法,那么本节的内容将类似于使用RTRT的产品编写的内容。用于放行的化学计量学模型将包含在本节中。本节中包含的模型校准、验证和维护信息量必须与PQS中提供的信息平衡。换言之,CTD中需要多少信息,而PQS中就可以处理多少信息。
3.2.P.5.3部分分析方法验证,适用于药品连续制造工艺,旨在确保分析方法具有可重复性、稳健性和准确性等。当前实施PAT程序所用的指南文件和方法可作为本节的示例。
3.2.P.5.4部分:批次分析,适用于固体制剂连续制造工艺,尽管从高级控制系统报告的数据量要比用于传统分析的数据量大得多。
3.2.P.5.5部分:杂质的鉴定,发起人将需要证明没有生成新的杂质或没有生成比现有杂质更高水平的杂质(例如,证明连续制造工艺中的产热或其他环境条件变化等因素不会导致稳定性问题,特别是对于生产持续时间的延长)。
3.2.P.8部分稳定性,适用于连续制造工艺。
然而,用于稳定性方面的批量大小的传统描述需要适应灵活的批量大小。
6.上市后变更
6.1.支持上市后变更的持续生产的关键要素
根据ICH Q8(R2)、Q9和Q10指南文件,预计将采用QBD原则开发连续制造工艺。这些指导文件适用于连续生产,并确保基于风险和科学的质量方法,鼓励在产品生命周期中持续改进。
使用连续制造的产品开发将更加强调了解关键变量(如原材料属性)和工艺参数之间的相互作用,并确定不影响产品质量的每个参数的允许可变性。可能不需要为所有工艺参数建立设计空间,但应确定和理解配方和工艺固有的关键可变性来源,以告知如何在常规生产过程中对其进行管理。
对连续制造工艺制定的控制策略将基于经验数据、工艺模型和中控PAT数据的综合。这将确保对关键变量进行识别、监控和控制,以确保在规定范围内生产具有统一特性和质量的物料。PAT(包括软测量技术)是连续制造的一个组成部分,提供对关键属性的及时测量或代替关键属性,并促进对制造工艺的科学理解。所用的实时连续监控支持持续改进,并可用于上市后变更。
6.2.上市后变更的重点领域
6.2.1.连续制造工艺上市后的变更
以下是随着时间的推移,随着连续制造工艺经验的积累,预计会发生的变更的例子。
o批量增加超过最初验证的数量。
o初始设计空间内/外工艺参数的变化
o中间控制的变更或删除的变更(例如,将合成的RTD模型转换为采用NIR模型和RTD模型进行合成的冗余控制)
o放行测试策略的变更(例如,对混合物进行分析检测变更为对最终产品进行分析检测)
o辅料(等级、供应商)、API标准的变更
o可移植性
o使用相同(或技术兼容)的设备链的场地变更
o在同一设施中增加另一个相同的设备链
o不同链之间--链等效标准
根据FDA批准时所达到的工艺理解水平,上面列出的一些预期变更以及其他类似性质的变更可能构成既定条件的要素,而其中一些可能不需要描述既定条件。由于开发和制造过程中连续工艺产生的大量信息,企业很可能相对较快地获得大量经验,从而导致传感和控制策略的快速优化。同样,随着该领域的发展,越来越多的关于不同类型产品和工艺的传感和控制要求以及各种版本的类似设备的相对性能能力的数据可用,上面列出的一些预期变更可能成为常规变更,而不是对既定条件的变更。
6.2.2.从批准的批处理工艺变更为连续工艺
变更的类型和程度以及化合物的风险概况将决定可以利用来自批次工艺多少数据,以及需要哪些额外研究来支持从批次生产工艺到连续生产工艺的这一变更。如果产品成分、制造工艺和批次工艺的标准没有变更或只有极小的变更,则可以利用批次工艺的稳定性数据等信息来支持连续制造的产品的保质期。如果处方变更很小,并且体外性能清楚且令人信服地证明产品性能可能不受影响时,生物豁免可能是合适的。两种制造方法之间的详细工艺和质量比较将对差异进行描述,并指导风险评估和所需数据的制定,以支持从批次制造工艺过渡到连续的制造工艺。产品放行和工艺控制要求对于连续制造来说预计会有显著的不同,特别是如果批准的产品是通过传统测试放行的,并且过程控制很少。
6.2.3.开发过程中的变更-批次工艺到连续工艺
在开发过程中,从批次工艺过渡到连续工艺的决定可能发生在关键临床数据生成之前或之后。如果没有产生关键的临床数据,也没有进行正式的稳定性研究,则可以通过体外相似度或生物等效性研究来架起批次和连续工艺之间的桥梁。然而,如果通过批次工艺生产的产品获得了关键的临床数据,则连接到连续生产工艺将需要广泛的体外特性,在某些情况下,可能需要进行体内研究。
6.3.风险评估
药品连续制造工艺可以使用ICH Q8 (R2)、Q9和Q10指南文件中概述的原则来开发。这种方法将确保适当地识别、确定和减轻风险。风险评估,基于先前的知识和对输入物料性能、设备、工艺和环境因素之间关系的深入理解,将告知产品质量和患者安全和有效性的变化的影响。从持续监测生产参数和持续验证计划中获得的大量数据将是评估产品质量变化风险的宝贵资源。
还可以进行其他研究,以进一步了解确定的风险或减轻风险。在变更的实施过程中,可能会建议进行额外的测试,以确保对已批准流程的变更已被很好地理解和控制。
6.4.提交要求
现有的变更通知类别(PAS、CBE-30、CBE-0、AR)可用于药品连续制造的上市后变更的提交。风险分类将通知变更通知类别,风险评估中的信息可用于证明所选的提交方式的合理性。
总结
可以说,上面这份指南尽管只提到口服固体制剂的连续制造的管理期望和法规要求,但是也从生命周期的各个阶段,把欧美制药行业对药品连续制造的全景进行了细致描述。希望此指南可以对困扰中的中国制药同仁提供有益的帮助。
来源:网络 编辑整理:德斯特cGMP 版权及免责声明:本公众号所有文章除标明原创外,均来自网络。登载本文的目的为传播行业信息,内容仅供参考,如有侵权请联系德斯特删除。文章版权归原作者及原出处所有。本公众号拥有对此声明的最终解释权。

德斯特cGMP团队一直致力于国际GMP认证咨询;针对美国GMP认证, EU-GMP认证, PIC/S认证, WHO认证以及中国GMP认证,可为客户提供完整的GMP认证解决方案;同时,在产品注册和产品技术转移,以及新建项目的设计、验证服务可提供专业的咨询服务。